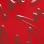
Slip Dressed Up

OPI
Slip Dressed Up
13,99 $
Livraison gratuite au Canada
sur commandes de 49 $ et +
Voir les politiques de livraison
PRODUITS COMPLÉMENTAIRES
Description
Les vernis réguliers OPI sont des références incontournables dans l'univers de la manucure. Offrant une large palette de couleurs vibrantes et tendance, leur formule professionnelle garantit une application fluide, une couverture parfaite et une tenue longue durée. Faciles à appliquer, ces vernis sont idéaux pour sublimer vos ongles au quotidien avec une finition brillante et impeccable.
Caractéristiques
- Jusqu'à 7 jours de tenue
- Sèche rapidement
Mode d'utilisation
- Utiliser sur ongles propres et taillés
- Appliquer une couche de base OPI pour une meilleure adhérence
- Appliquer deux couches de vernis OPI
- Appliquer une couche de finition OPI pour plus de brillance et de tenue
- Terminer en appliquant l'huile pour ongles et cuticules ProSpa de OPI
- Pour retirer le vernis des ongles, utilisez votre dissolvant habituel
* La couleur telle que présentée dans l'image peut varier de la teinte réelle du vernis.